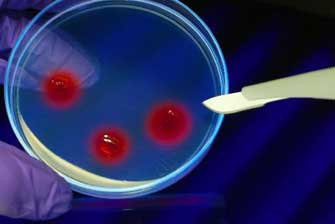
Εντοπίστηκαν και νέα γονίδια που σχετίζονται με τον αυτισμό

Nέα κριτήρια διάγνωσης για την «ανδρική εμμηνόπαυση»
Αθήνα: Η χαμηλή σεξουαλική επιθυμία, η καταθλιπτική διάθεση και γενικότερα η έλλειψη ενέργειας, που αισθάνονται αρκετοί μεσήλικες και ηλικιωμένοι, μπορεί να είναι απλώς σημάδια της φυσιολογικής γήρανσης και όχι της «ανδρικής εμμηνόπαυσης», που προκαλείται από την πτώση των επιπέδων της τεστοστερόνης.

Αριθμός Πιστοποίησης Μ.Η.Τ.232442
Αριθμός Πιστοποίησης Μ.Η.Τ.232442